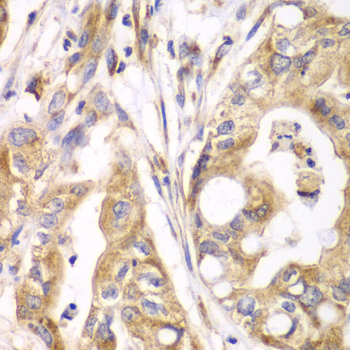

Product Detail
Product NameTXNRD2 Antibody
Host SpeciesRabbit
ClonalityPolyclonal
IsotypeIgG
PurificationAffinity purification
ApplicationsWB,IHC,IF
Species ReactivityHuman,Mouse
SpecificityThe antibody detects endogenous level of total TXNRD2 protein.
Immunogen TypeRecombinant Protein
Immunogen DescRecombinant fusion protein of human Thioredoxin reductase 2 (Thioredoxin reductase 2 (TXNRD2 ) ) (NP_006431.2).
Target NameTXNRD2
ConjugateUnconjugated
Other NamesTXNRD2;SELZ;TR;TR-BETA;TR3;TRXR2
Accession NoUniprot:Q9NNW7
GeneID:10587
Uniprot
Q9NNW7
Gene ID
10587
Sdspage MW56kDa
Concentration1.0mg/ml
FormulationPBS with 0.02% sodium azide,50% glycerol,pH7.3.
StorageStore at -20˚C. Avoid freeze / thaw cycles.
Application Details
WB 1:500 - 1:2000
IHC 1:50 - 1:200
IF 1:50 - 1:200
Immunohistochemistry of paraffin-embedded human liver damage using Thioredoxin reductase 2 (Thioredoxin reductase 2 (TXNRD2 ) ) antibody.
Western blot analysis of extracts of various cell lines, using Thioredoxin reductase 2 (Thioredoxin reductase 2 (TXNRD2 ) ) antibody.
Immunohistochemistry of paraffin-embedded human liver cancer using Thioredoxin reductase 2 (Thioredoxin reductase 2 (TXNRD2 ) ) antibody.
Immunofluorescence analysis of L929 cells using Thioredoxin reductase 2 (TXNRD2 ) antibody.
Immunofluorescence analysis of U2OS cells using Thioredoxin reductase 2 (TXNRD2 ) antibody.
The protein encoded by this gene belongs to the pyridine nucleotide-disulfide oxidoreductase family, and is a member of the thioredoxin (Trx) system. Three thioredoxin reductase (TrxR) isozymes are found in mammals. TrxRs are selenocysteine-containing flavoenzymes, which reduce thioredoxins, as well as other substrates, and play a key role in redox homoeostasis. This gene encodes a mitochondrial form important for scavenging reactive oxygen species in mitochondria. It functions as a homodimer containing FAD, and selenocysteine (Sec) at the active site. Sec is encoded by UGA codon that normally signals translation termination. The 3' UTRs of selenoprotein mRNAs contain a conserved stem-loop structure, the Sec insertion sequence (SECIS) element, which is necessary for the recognition of UGA as a Sec codon rather than as a stop signal. Alternatively spliced transcript variants encoding different isoforms, including a few localized in the cytosol and some lacking the C-terminal Sec residue, have been found for this gene.
If you have published an article using product 32885, please notify us so that we can cite your literature.
et al,The effect of exposure time and concentration of airborne PM2.5 on lung Injury In mice: A transcriptome analysis. In Redox Biol on 2019 Sep by Wang H, Shen X et al..PMID:31279222
, (2019),
PMID:
31279222

Yes
Yes



